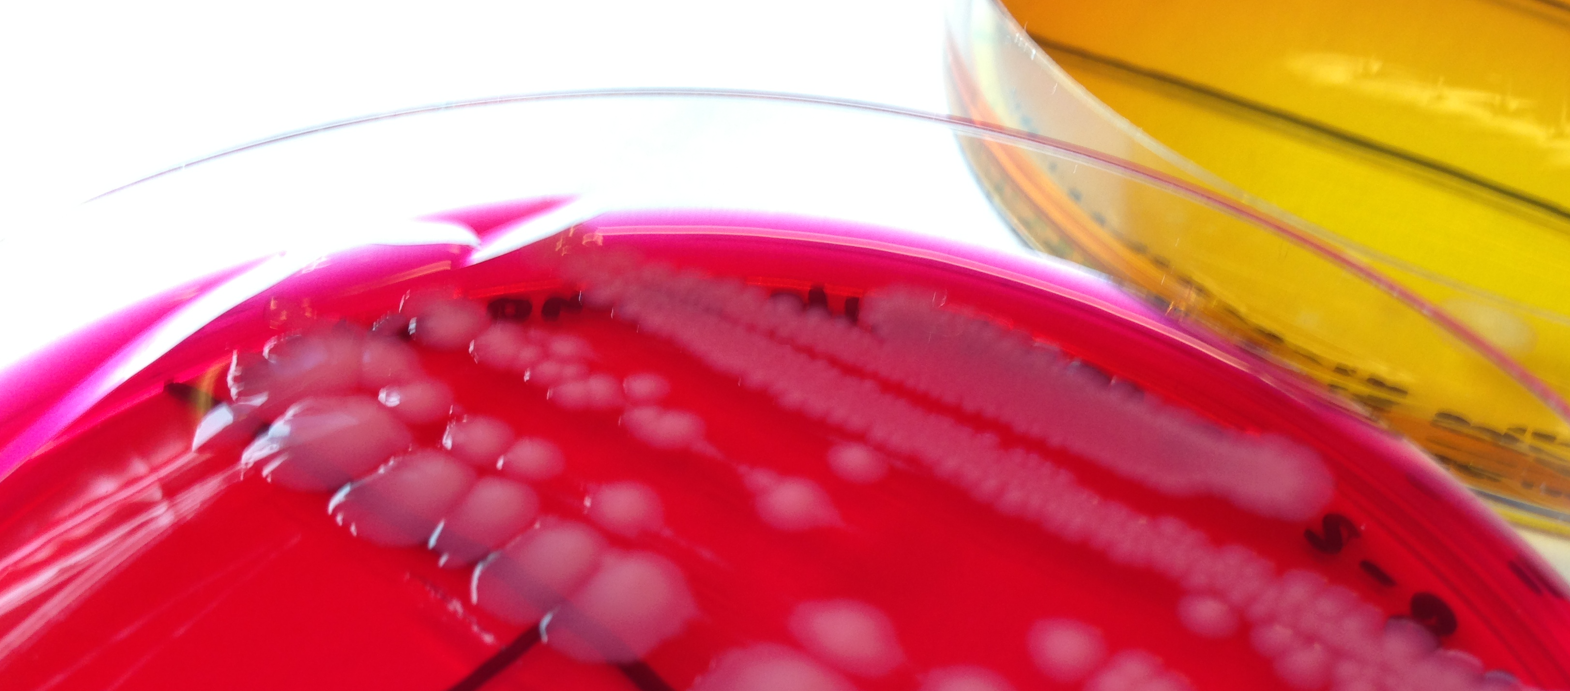
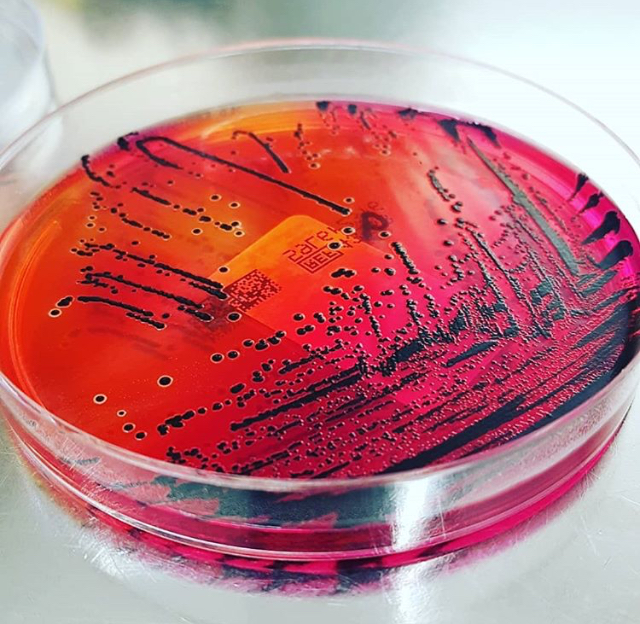

Bij een salmonella-uitbraak in de Verenigde Staten en Canada zijn ten minste acht mensen overleden. Er zijn honderden besmettingen gemeld, die worden gekoppeld aan een meloensoort, de cantaloupe. Veel van de mensen die ziek werden, zeiden voorgesneden stukjes meloen te hebben gegeten uit plastic bakjes. In beide landen zijn nu grote terugroepacties gestart voor zowel voorgesneden stukjes als hele vruchten (CDC, 7 december 2023)
Het Voedingscentrum raadt mensen aan groente en fruit altijd eerst te wassen met water. Dat geldt ook voor fruit dat je nog gaat schillen, zoals meloen.
Grensreactie
Veel voedselinfecties worden veroorzaakt door bacteriën die behoren tot het geslacht Salmonella. Men schat dat in Nederland ruim honderdduizend voedselinfecties per jaar worden veroorzaakt door Salmonella.
Met het werkboek Basisvaardigheden Microbiologie leren studenten de verschillende stappen uit het microbiologisch onderzoek naar Salmonella. In dit onderzoek wordt geen kolonietelling gedaan, maar wordt onderzocht of Salmonella al dan niet aanwezig is in een voedingsmiddel, de zogenaamde grensreactie.

Na uitvoeren van dit experiment zijn studenten bekend met de grensreactie op Salmonella en zijn ze in staat de microbiologische hygiëne van voedingsmiddelen zoals meloenen te bepalen. De achtergrondkennis bij dit experiment testen studenten zelf met een online quiz.